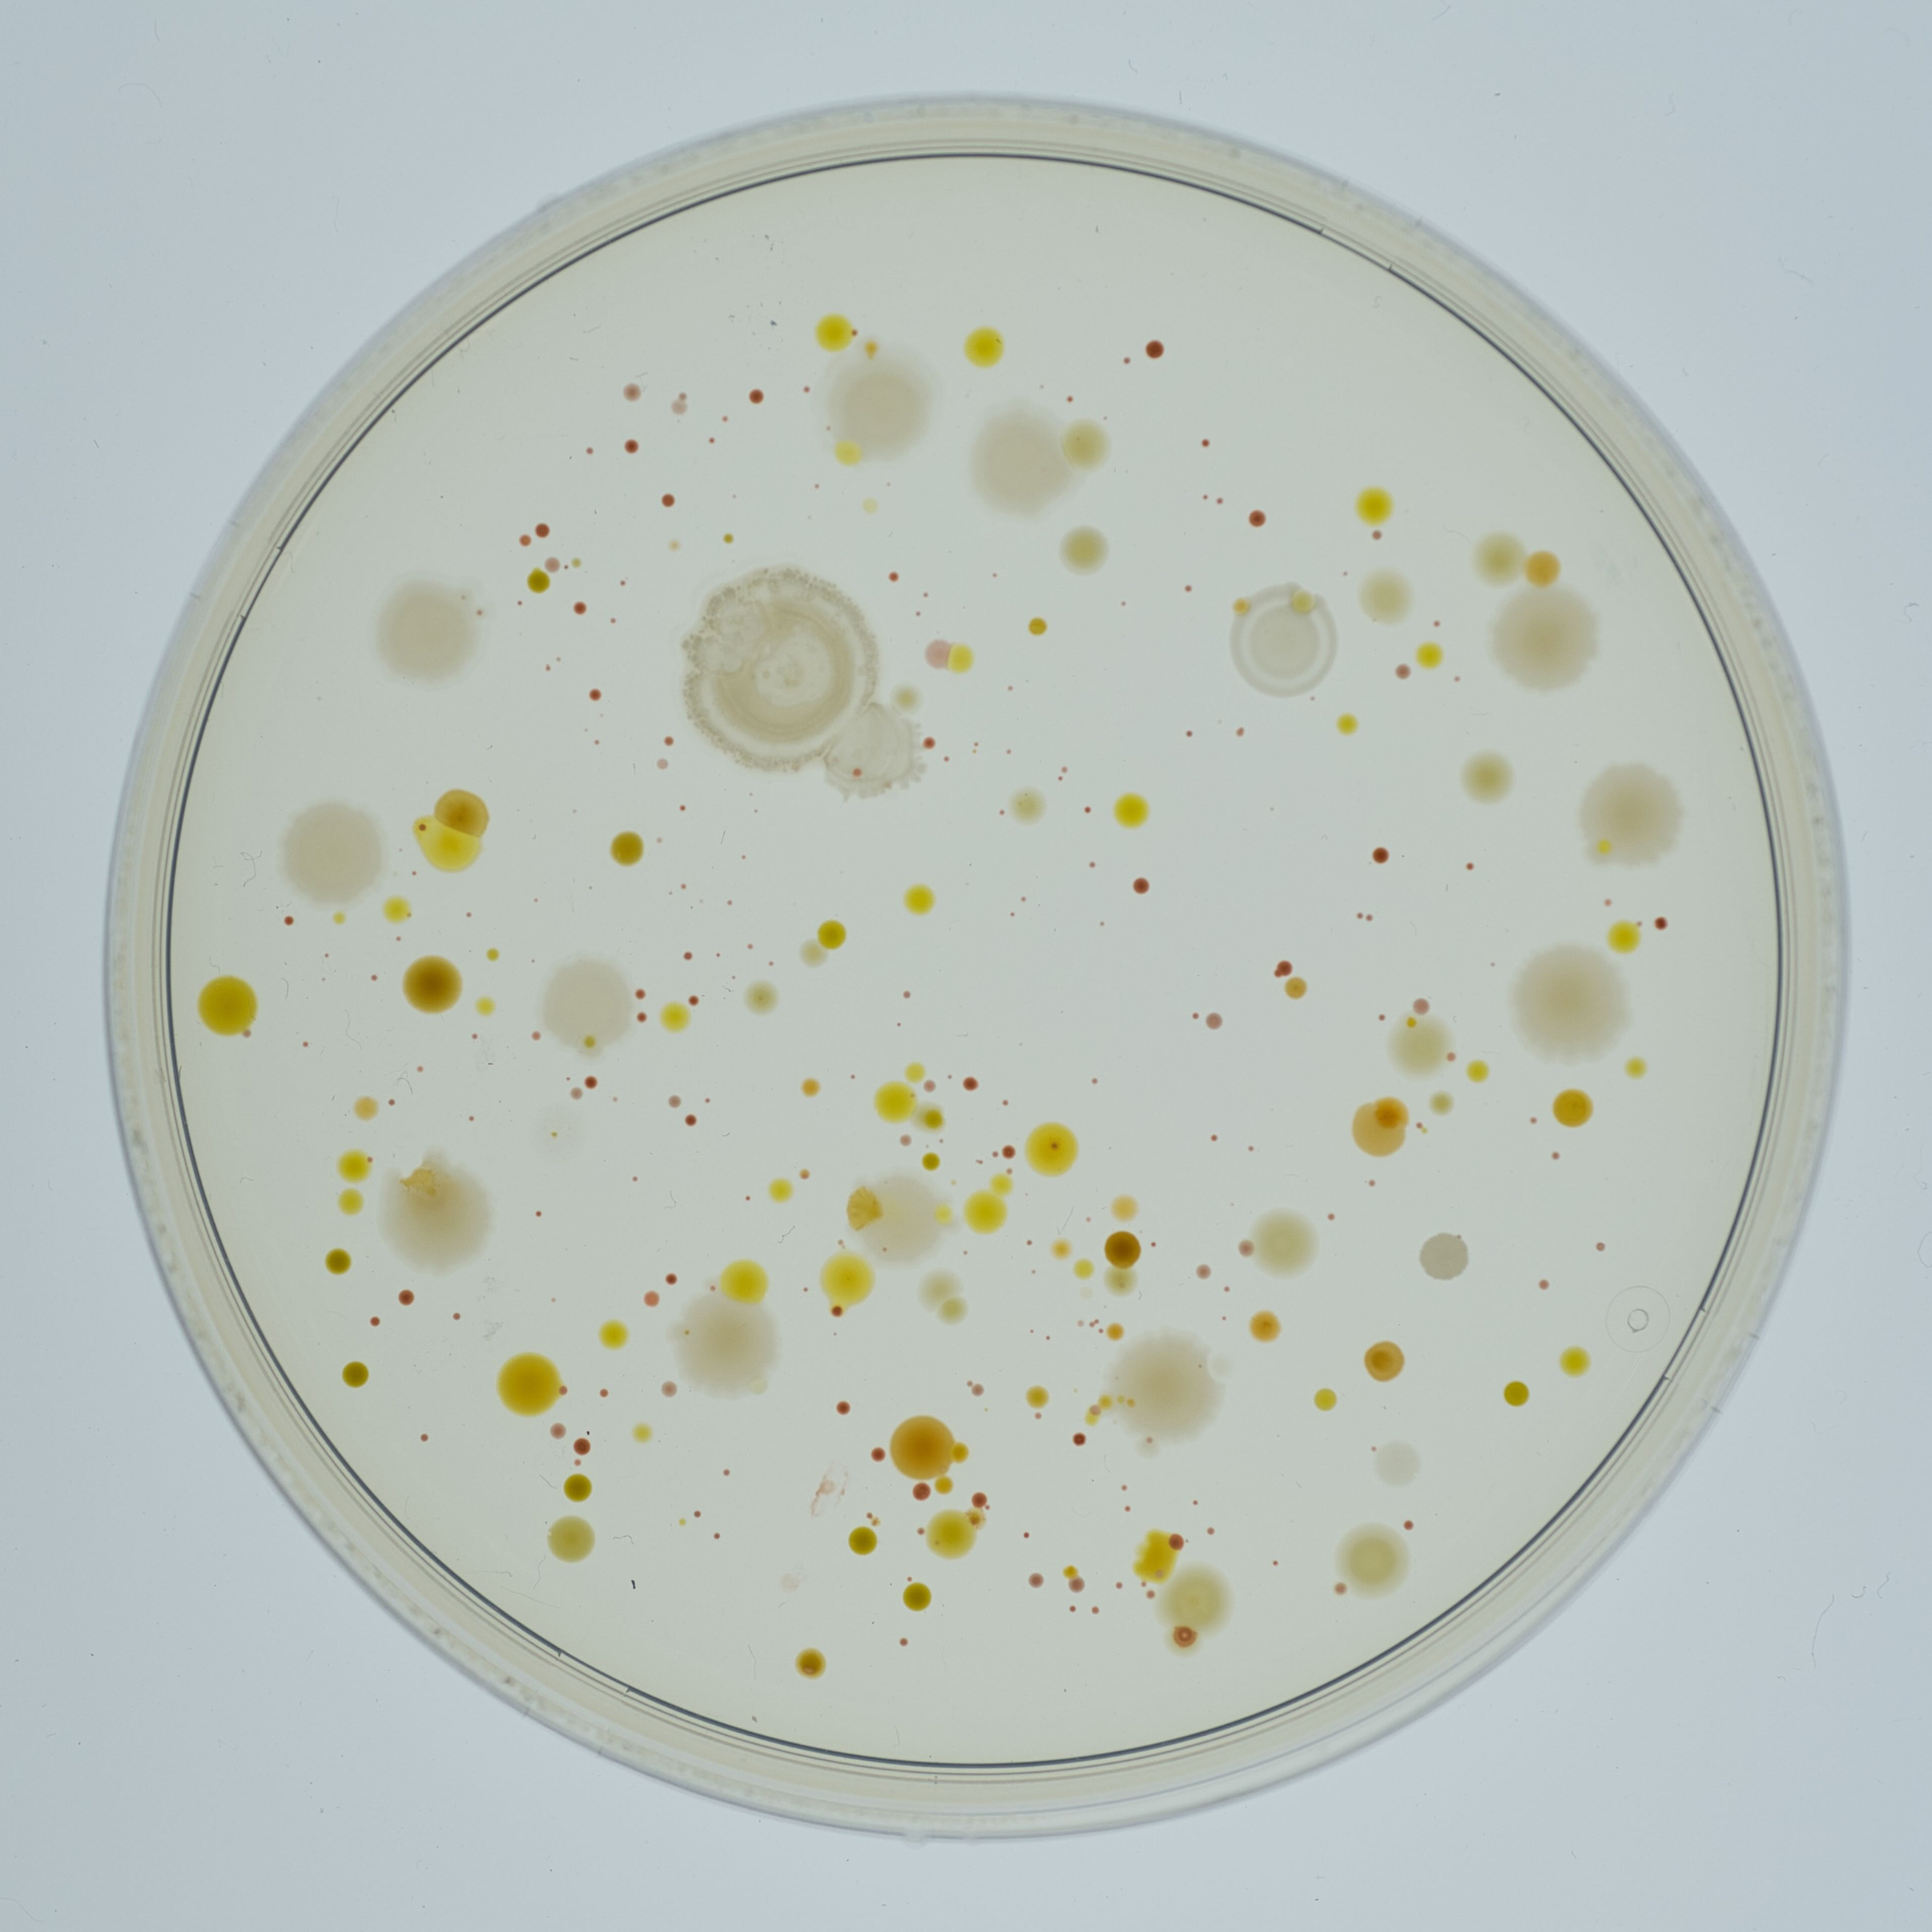

Today's Creation Moment
In the beginning... God Created. Join us as we proclaim evidence for the truth of the Bible through the wonders of God's creation! Each program features scientific facts proving that the natural world was deliberately designed and is not a product of evolutionary chance. For more creation resources, visit our website at creationmoments.com To support our ministry, visit https://store.creationmoments.com/donate/general-fund
The Personality of Bacteria

Research shows bacteria can learn, remember, and even display unique personalities despite identical genetics. Such individuality cannot be explained by evolution. Instead, it reflects God’s care for even the smallest details of creation.
Bamboo’s Message to the World

All members of a bamboo species flower simultaneously worldwide, then die, leaving only seeds. Such synchronization argues for a recent creation, not millions of years of evolutionary divergence.
Plants that Fool Insects

Orchids and other plants employ deceptive strategies—like mimicking female insects or prey—to achieve pollination. Their interdependence demonstrates a Creator’s work, not evolutionary accident.
Image: Spider orchid (Brassia maculata), Photo by David J. Stang, CC BY-SA 4.0, Wikimedia Commons.
Spiders the Size of a House?

While insects vary greatly in size, oxygen delivery systems limit how large they can grow. Spiders the size of houses are impossible due to these physical constraints. This balance shows God’s wisdom in equipping each creature for its needs.
The Mind of a Bacteria
Bacteria demonstrate both long-term and short-term memory, recalling past strategies for survival. Such learning and decision-making defy claims that they are “simple” life forms.
Is it Orchid or Insect?

Certain orchids mimic female insects so perfectly that male pollinators are deceived into ensuring pollination. These deceptions are too precise to be explained by chance.
Image: Cryptostylis leptochila, Geoff Derrin, CC BY-SA 4.0, Wikimedia Commons.
The Vine that Keeps Pet Butterflies
Some tropical vines depend entirely on pollen-eating butterflies, which in turn rely on the vines for food. Female flowers mimic male flowers to attract pollinators. Such tightly matched relationships testify to a Creator’s purposeful design.
Image: Psiguria vine with Heliconius butterfly, KimonBerlin, CC BY-SA 2.0, Wikimedia Commons.
What Amoebas Know

Despite lacking brains, amoebas avoid wandering in circles when searching for food, showing a form of memory. This surprising ability reflects God’s design even in single-celled organisms. Likewise, God’s Word prevents us from wandering aimlessly in life.
Image: Amoeba proteus, SmallRex, CC BY-SA 4.0, Wikimedia Commons.
Dancing Bees

Bees communicate by dancing to show the location of nectar sources. When researchers tricked them, the hive demonstrated awareness by ignoring false directions, revealing unexpected intelligence. This highlights God’s gift of wisdom even to small creatures.
Discovery Confirms Creation Claims

Creationists predicted that “modern” human fossils would be found in older layers than evolution allows. New discoveries have indeed pushed back the age of humanity far beyond evolutionary expectations. This supports the biblical account that humans have been here from the beginning.
Image: Qafzeh 9 Homo sapien, Ryan Somma from Occoquan, USA, CC BY-SA 2.0, Wikimedia Commons.
Bacteria’s Eyes and Ears

Bacteria are far from simple—they have sensors like eyes and ears, and process information like a brain. They can detect differences too small for humans to notice. Their sophistication points to an intelligent Designer, not accidental origins.
Image: A natural community of bacteria growing on a single grain of sand, Anthony D'Onofrio, CC BY 2.0, Wikimedia Commons.
A Whale of a Problem

Whales are mammals but live entirely in the sea, posing a major problem for evolutionary claims. Their existence shows that not all mammals are related by descent. Instead, whales confirm God’s creation of distinct kinds from the beginning.
Three Million Children

The Catasetum orchid relies on a few male flowers and even fewer female flowers, yet can produce up to three million seeds from successful pollination. Its survival depends on precise design and timing. If God cares for such details in plants, how much more does He care for us?
Image: Female catasetum orchids and insect, Clara egrejas, CC BY-SA 4.0, Wikimedia Commons.
A Desert full of Frogs?

Tree frogs and desert frogs thrive in unlikely environments thanks to special provisions from the Creator. Bromeliads provide treetop pools for tree frogs, while desert frogs store water and hibernate underground until rain returns.
Image: Cyclorana platycephala (water-holding frog), en-User-Tnarg 12345, CC BY-SA 3.0, Wikimedia Commons.
Hydraulic Spiders

Spiders use hydraulic pressure to extend their legs, and some plants even catapult seeds using the same principle. This advanced engineering was designed by God long before humans discovered hydraulics.
The Strange Behavior of Orchids

Orchids use highly specialized strategies for pollination, from bright colors for birds to deceptive shapes for insects. Evolutionary terms like “co-evolution” fail to explain such complexity. These wonders point us to the Creator who designed them and calls us into relationship with Himself.
Image: Bee orchid (Ophrys apifera), Marie-Lan Taÿ Pamart, CC BY 4.0, Wikimedia Commons.
Can Bacteria Think?

Experiments show that bacteria can make decisions, such as enduring discomfort to reach food. This intelligence challenges the evolutionary expectation that only higher creatures can think. Instead, it demonstrates that God equips every living thing with what it needs.
Image: Portrait of Wilhelm Pfeffer, Science History Institute, PD, Wikimedia Commons, changes made.
Creative Procreation

Sexual reproduction in plants presents a problem for evolution, yet God’s design solves it beautifully. The Arum lily uses an ingenious system with insects to ensure pollination. Such complexity points to a purposeful Creator rather than random chance.
Image: Zantedeschia aethiopica (arum lily),Krzysztof Ziarnek, Kenraiz, CC BY-SA 4.0, Wikimedia Commons.
Mysteries of the Piranha

Piranhas defy evolutionary expectations since multiple species live in the same way rather than diversifying. Their surprising selfless feeding habits also puzzle evolutionists. These traits instead reflect the Creator’s variety, creativity, and provision.
One God Against the gods

The plagues of Egypt directly targeted Egypt’s false gods, proving the superiority of Israel’s God. Each plague dismantled the supposed power of a particular deity, leaving no doubt that the true Creator rules over all.
Image: The Seventh Plague, John Martin, PD, Wikimedia Commons.
Real Sloth

The three-toed sloth moves painfully slow, yet is perfectly suited to its arboreal lifestyle. Despite its helpless appearance, it thrives in the forests of South America. Its life reminds us of our dependence on Christ for salvation and our call not to be spiritually slothful.
For more creation resources, visit https://creationmoments.com/
Is There Life in Space?

Past hoaxes and modern searches reveal no real evidence of life beyond earth. Evolutionists hope for extraterrestrial life as proof of their beliefs, but the Bible suggests life is unique to earth. Our planet’s fine-tuning reflects God’s special design for humanity.
For more creation resources, visit https://creationmoments.com/
Image: Great Moon Hoax, Lith. de Thierry Frères., PD, Wikimedia Commons.
The Loving Crocodile

Crocodiles tenderly guard their eggs and gently help hatchlings emerge, even carrying them in their mouths to safety. Both parents may care for the young, showing a surprising amount of love.
For more creation resources, visit https://creationmoments.com/
Image: Baby crocodile, Veronik80000, CC BY-SA 4.0, Wikimedia Commons.
Complex Ant Society

Ant colonies function like massive superorganisms, with specialized roles for soldiers, workers, and caretakers. The largest known colony houses over 300 million ants in tens of thousands of nests. This remarkable order reflects intelligence beyond the ants themselves.
For more creation resources, visit https://creationmoments.com/
The Crocodile Bird

The crocodile bird cleans food scraps from crocodile mouths and alerts them to danger, benefiting both species. Such complex cooperation cannot be explained by evolution but shows intentional design.
For more creation resources, visit https://creationmoments.com/
Image: Charadrius aegyptius (crocodile bird), Biodiversity Heritage Library, CC0, Wikimedia Commons.
The Archer Fish

The archer fish shoots precise streams of water to knock insects into the water for food. Its mouth forms a blow tube with valve-like precision, allowing accurate aim. This ingenious design points to God’s detailed provision, even for a small fish.
For more creation resources, visit https://creationmoments.com/
Image: Banded Archer Fish, GinaFranchi, CC BY-SA 4.0, Wikimedia Commons.
Thinking God’s Thoughts After Him

Creatures display God’s inventive care, from glowing fish to long-distance-flying birds and swimming penguins. Each is perfectly suited to its environment with unique adaptations. Studying them helps us better understand God’s thoughts and creativity.
For more creation resources, visit https://creationmoments.com/
Image: Gentoo penguin, Ken FUNAKOSHI, CC BY-SA 2.0, Wikimedia Commons.
Faith: Christ or Man?

Many scientists admit evolution is not a testable scientific theory but a metaphysical system of belief. The fossil record itself shows sudden appearance of fully formed creatures, not gradual evolution. Evolution is faith in man, while creation rests on faith in God’s Word.
For more creation resources, visit https://creationmoments.com/
Image: The Story of Man, Hendrik Willem Van Loon, PD, Wikimedia Commons.
Death Before Adam?

If death existed before Adam, then sin would not be the cause of death, undermining the Gospel itself. Scripture ties death directly to Adam’s fall and new life to Christ. Evolution with death before man denies this vital truth.
For more creation resources, visit https://creationmoments.com/
Image: Adam and Eve in the earthly paradise, Johann Wenzel Peter, PD, Wikimedia Commons.
Certain: Six Creation Days

The Ten Commandments affirm that God created in six days and rested on the seventh, forming the basis of the Sabbath. If creation days were ages, God’s command about weekly rest would be meaningless. Scripture confirms creation occurred in six literal days.
For more creation resources, visit https://creationmoments.com/
Image: Ten commandments, prayer book of Martin Luther, Hans Sebald Beham, PD, Wikimedia Commons, changes made.
Do Christians Need Evolution?

Some Christians think they must reconcile the Bible with evolution, but the fossil record shows creatures appear suddenly, fully formed. Even evolutionists admit there are no undisputed transitional forms. Faithful Christianity requires no compromise with evolutionary theory.
For more creation resources, visit https://creationmoments.com/
Image: Fossils from Cretaceous age, Brocken Inaglory, CC BY-SA 3.0, Wikimedia Commons.
Does Evolution Allow the Supernatural?

Evolution relies solely on natural laws, leaving no room for God’s intervention in creation. Theistic evolution is therefore inconsistent both with evolution’s principles and the Bible’s teaching.
For more creation resources, visit https://creationmoments.com/
Did God Create by Evolution?

Many believe God used evolution to create, but thousands of scientists affirm direct creation in six days. Their work shows the Bible offers an intelligent, scientific alternative to evolution. God’s instrument of creation was not natural law but His Word through Christ.
For more creation resources, visit https://creationmoments.com/
Image: ICR Discovery Center lobby paintings, 1990'sguy, CC BY-SA 4.0, Wikimedia Commons.
Consider All the Dating Methods

Scientists use over 100 different dating methods, yet only a few are emphasized to support billions of years. Many methods yield ages of just thousands of years, aligning with biblical creation. True science supports a young earth consistent with Scripture.
For more creation resources, visit https://creationmoments.com/
Image: Earth, Blue Marble Western Hemisphere, NASA images by Reto Stöckli, based on data from NASA and NOAA., Terra MODIS, PD, Wikimedia Commons.
Monkeying with Typewriters

The idea that random chance can produce meaningful order, like monkeys typing Shakespeare, collapses under mathematical scrutiny. Even infinite time would not generate coherent results before producing endless nonsense.
For more creation resources, visit https://creationmoments.com/
Does Time Work Miracles?

Some evolutionists claim that with enough time, the impossible becomes possible. Yet science shows that time cannot make nonliving matter come alive. Only God has the power to create life.
For more creation resources, visit https://creationmoments.com/
Image: Frog Prince, Jack Zipes Historic Fairy Tale Postcard Collection, MCAD Library, CC BY 2.0, Wikimedia Commons, changes made.
A Janitorial Service in Space

The solar system continually sweeps up cosmic dust, much like cleaning a floor. Calculations show that if the system were billions of years old, space should be dust-free by now. The persistence of dust supports the Bible’s teaching of a young universe.
For more creation resources, visit https://creationmoments.com/
Image: Comets Kick up Dust in Helix Nebula, NASA and JPL-Caltech, Univ. of Ariz., PD, Wikimedia Commons, cropped.
Cooked Dinosaur

The sun might be shrinking. If the earth were millions of years old, life could not have survived long ago. Even small shrinkage rates point to an earth history measured in thousands, not billions, of years.
For more creation resources, visit https://creationmoments.com/
The Mystery of Red Sirius

Ancient records describe Sirius as a red star, but today it is a white dwarf—a transformation that should take 100,000 years, not under 2,000. This contradiction challenges evolutionary astronomy’s timelines. Sirius points instead to a younger universe consistent with biblical history.
For more creation resources, visit https://creationmoments.com/
Image: Sirius A and B, hubble photo, NASA, ESA, H. Bond (STScI), and M. Barstow (University of Leicester), PD, Wikimedia Commons, changes made.
Knowing the Religions of Our Times

Many modern belief systems, including secular humanism, function as religions even while denying God. Without recognizing the Creator, people invent their own values and definitions of life. Christians must understand these competing faiths in order to share how Christ truly answers life’s questions.
For more creation resources, visit https://creationmoments.com/
Image: Coexist symbol (question mark added), Iago Casabiell González, CC BY-SA 4.0, Wikimedia Commons.
